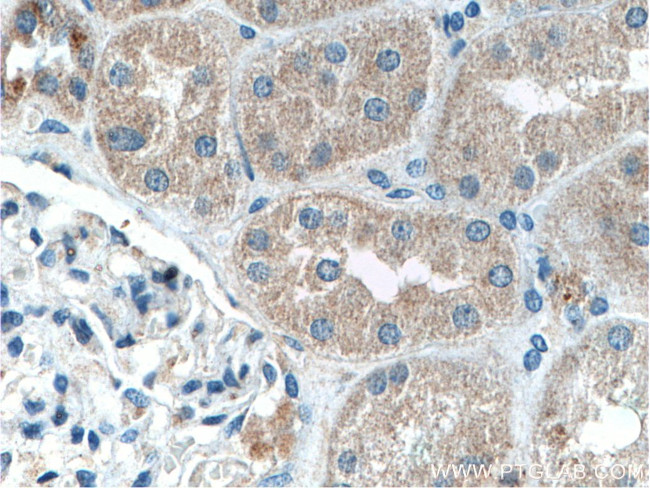
IFRG15 Antibody in Immunohistochemistry (Paraffin) (IHC (P))
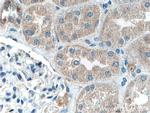
IFRG15 Antibody in Immunohistochemistry (Paraffin) (IHC (P))
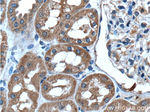
IFRG15 Antibody in Immunohistochemistry (Paraffin) (IHC (P))

Search
Proteintech
IFRG15 Polyclonal Antibody
{{$productOrderCtrl.translations['antibody.pdp.commerceCard.promotion.promotions']}}
{{$productOrderCtrl.translations['antibody.pdp.commerceCard.promotion.viewpromo']}}
{{$productOrderCtrl.translations['antibody.pdp.commerceCard.promotion.promocode']}}: {{promo.promoCode}} {{promo.promoTitle}} {{promo.promoDescription}}. {{$productOrderCtrl.translations['antibody.pdp.commerceCard.promotion.learnmore']}}
产品信息
21825-1-AP
种属反应
宿主/亚型
分类
类型
抗原
偶联物
形式
浓度
规格
纯化类型
保存液
内含物
保存条件
运输条件
产品详细信息
Immunogen sequence: MFSDNSHCP DCGQQWFPSL ELGHWLYQTE LVENECYQVF LDRINRADYC PECYPDNPAN RSLVLPWSFP LEWAPQNLTR WTFEKACHPF LLGPPLVRKR IHDSRVAGFN PALQLILTRT DKTLNKKLGQ NK (1-131 aa encoded by BC098348)
靶标信息
Torsin-1A-interacting protein 2, isoform IFRG15, also known as TOR1AIP2 or LULL1, is a protein encoded by the TOR1AIP2 gene, existing in different forms (isoforms) due to alternative splicing, with IFRG15 being an interferon-responsive one, while the main form (isoform b) is an integral ER membrane protein that regulates the ATPase TorsinA, crucial for early-onset dystonia if defective. This protein acts as a cofactor for TorsinA, influencing its localization and activity, and plays roles in the endoplasmic reticulum/nuclear envelope dynamics and potentially in odontogenesis (tooth development) and craniofacial development.
仅用于科研。不用于诊断过程。未经明确授权不得转售。
篇参考文献 (0)
生物信息学
蛋白别名: 15 kDa interferon-responsive protein; IFRG15; interferon responsive gene 15; lumenal domain like LAP1; Lumenal domain-like LAP1; torsin A interacting protein 2; Torsin-1A-interacting protein 2; Torsin-1A-interacting protein 2, isoform IFRG15; unnamed protein product
基因别名: IFRG15; LULL1; NET9; TOR1AIP2
UniProt ID: (Human) Q9H496
Entrez Gene ID: (Human) 163590